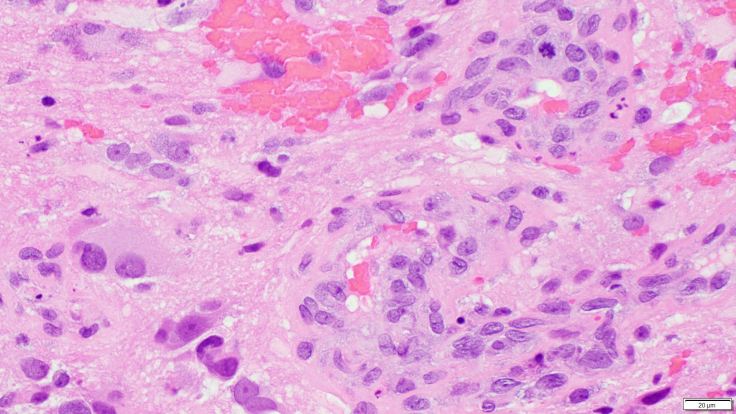
Glioblastoma

Glioblastomas are high grade astrocytomas that often exhibit microvascular proliferation, characterized by atypical hypertrophic and hyperplastic endothelial cells. A mitotic figure within a proliferating endothelial cell is present in the top right corner of the image.

Leave a comment